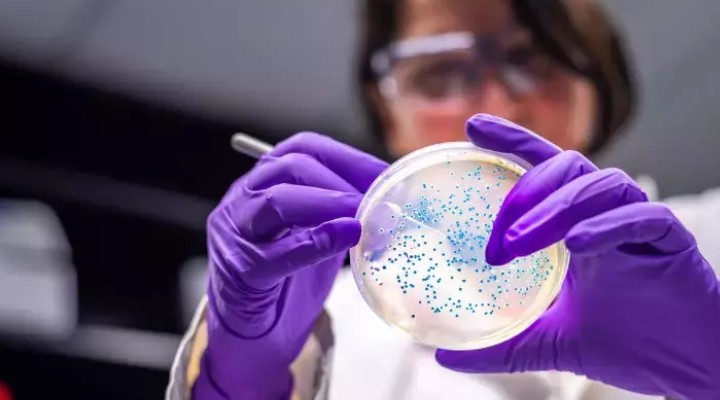

UKHSA açıklamasında “Mevcut araştırmada örneklerin tüm genom dizilimi, çoğu vakanın tek bir salgının parçası olduğunu gösteriyor. Vakaların geniş coğrafi yayılımına dayanarak, bu salgının ulusal düzeyde dağıtılan bir gıda maddesiyle veya birden fazla gıda maddesiyle bağlantılı olması muhtemeldir.
Bu salgının kaynağı henüz doğrulanmadı ancak şu anda salgının açık çiftlikler, içme suyu veya kirli deniz suyu, göl veya nehirlerde yüzmeyle bağlantılı olduğuna dair bir kanıt bulunmuyor” dedi.
Bu salgın kapsamında 25 Mayıs’tan itibaren 113 vakanın bildirildiğini ifade eden sağlık yetkilileri, koli basili bulaşarak hastalananların yaş aralığının 2 ila 79 olduğunu belirtip çoğunluğun genç yetişkinler olduğunu açıkladı. UKHSA, genel olarak yıllık bazda ortalama 1500 vaka gördüklerini ancak bu salgında genom dizilim çalışması tamamlanınca daha fazla vaka sayısı beklediklerini ifade etti.
 |
 |
 |
 |
|||||
|
|
|||||||
 Küfür, hakaret içeren; dil, din, ırk ayrımı yapan; yasalara aykırı ifade ve beyanda bulunan ve tamamı büyük harflerle yazılan yorumlar yayınlanmayacaktır. Neleri kabul ediyorum: IP adresimin kaydedileceğini, adli makamlarca istenmesi durumunda ip adresimin yetkililerle paylaşılacağını, yazılan yorumların sorumluluğunun tarafıma ait olduğunu, yazımın, yetkililerce, fikrim sorulmaksızın yayından kaldırılabileceğini bu siteye girdiğim andan itibaren kabul etmiş sayılırım. |
| # | TAKIM | O | G | B | M | A | Y | AV | P |
|---|---|---|---|---|---|---|---|---|---|
| 1 | Galatasaray | 34 | 24 | 5 | 5 | 77 | 30 | 47 | 77 |
| 2 | Fenerbahçe | 34 | 21 | 11 | 2 | 77 | 37 | 40 | 74 |
| 3 | Trabzonspor | 34 | 20 | 9 | 5 | 61 | 39 | 22 | 69 |
| 4 | Beşiktaş | 34 | 17 | 9 | 8 | 59 | 40 | 19 | 60 |
| 5 | Rams Başakşehir | 34 | 16 | 9 | 9 | 58 | 35 | 23 | 57 |
| 6 | Göztepe | 34 | 14 | 13 | 7 | 42 | 32 | 10 | 55 |
| 7 | Samsunspor | 34 | 13 | 12 | 9 | 46 | 45 | 1 | 51 |
| 8 | Çaykur Rizespor | 34 | 10 | 11 | 13 | 46 | 52 | -6 | 41 |
| 9 | Tümosan Konyaspor | 34 | 10 | 10 | 14 | 43 | 50 | -7 | 40 |
| 10 | Kocaelispor | 34 | 9 | 10 | 15 | 26 | 38 | -12 | 37 |
| 11 | Corendon Alanyaspor | 34 | 7 | 16 | 11 | 41 | 41 | 0 | 37 |
| 12 | Gaziantep FK | 34 | 9 | 10 | 15 | 43 | 58 | -15 | 37 |
| 13 | Kasımpaşa | 34 | 8 | 11 | 15 | 33 | 49 | -16 | 35 |
| 14 | Natura Dünyası Gençlerbirliği | 34 | 9 | 7 | 18 | 36 | 47 | -11 | 34 |
| 15 | ikas Eyüpspor | 34 | 8 | 9 | 17 | 33 | 48 | -15 | 33 |
| 16 | Hesap.com Antalyaspor | 34 | 8 | 8 | 18 | 33 | 55 | -22 | 32 |
| 17 | Zecorner Kayserispor | 34 | 6 | 12 | 16 | 27 | 62 | -35 | 30 |
| 18 | Mısırlı.com.tr Fatih Karagümrük | 34 | 8 | 6 | 20 | 31 | 54 | -23 | 30 |
| 19 |

 Künye
Künye İletişim
İletişim Facebook
Facebook Twitter
Twitter RSS
RSS Sitene Ekle
Sitene Ekle Günün Haberleri
Günün Haberleri